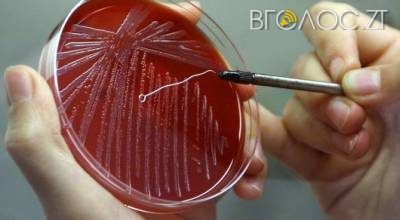

“До інфекційного відділення Коростенської ЦРЛ 4 жовтня госпіталізували 35-річну жінку з підозрою на сибірську виразку (шкірна форма). Захворіла 1 жовтня, а звернулася до лікарні 4 жовтня”, – йдеться у повідомленні.
До слова, у сім’ї проживає 5 осіб (мати хворої, чоловік та двоє неповнолітніх дітей). Для проведення розслідування випадку захворювання сформовано бригаду із спеціалістів Головного управління Держпродспоживслужби в Житомирській області, ДУ «Житомирський обласний лабораторний центр МОЗ України» та розпочато роботу в осередку захворювання. Ситуація перебуває на контролі Головного управління Держпродспоживслужби в Житомирській області.
Довідково: Сибірка (Anthrax, сибірська виразка, телій) – гостре інфекційне захворювання, що характеризується гарячкою, септицемією, інтоксикацією організму, серозно-геморагічним запаленням підшкірної та субсерозної сполучної тканин і внутрішніх органів, утворенням набряків та карбункулів.
Нагадаємо, у житомирській школі №33 учні отруїлися рослинами. В Андрушівському районі ціла родина отруїлася чадним газом.